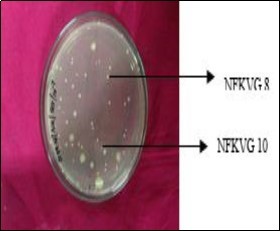

Isolation and Screening of Phb Producing Halotolerant Bacterial Strains from A Saline Environment
Abstract
Plastic materials have been used as packaging materials and also have other numerous applications because of their durability and stability. Plastic products are non degradable and they continue to exist in the environment thereby causing a serious threat to the ecosystem. Bioplastics which are biodegradable plastics are emerging out as a boon to overcome the problem of plastic accumulation. Polyhydroxybutyrate or PHB is a bioplastic that serves as an alternative to synthetic plastics. PHB is a lipid reserve material that gets accumulated within the cell wall of micro organisms under stress conditions. Halophilic microorganisms can be of much use in the production of PHB as it is cost – effective and recovery of PHB is much easier in halotolerant organisms. Hence this study focuses on the isolation of PHB producing halotolerant bacterial organisms from marine sources. Screening of PHB positive isolates was done by Sudan Black B and Nile blue A staining. Large scale production of PHB by the efficient bacterial strain was done by using wastewater as the substrate.
Author Contributions
Academic Editor: Ning Shen, Duke University
Checked for plagiarism: Yes
Review by: Single-blind
Copyright © 2017 Nabila Fathima S, et al.
This is an open-access article distributed under the terms of the Creative Commons Attribution License, which permits unrestricted use, distribution, and reproduction in any medium, provided the original author and source are credited.
Competing interests
The authors have declared that no competing interests exist.
Citation:
Introduction
Modernization and progress has its share of disadvantages and one of the main aspects of concern is the pollution it is causing to earth1. Plastic materials that have been universally used in our daily lives are now causing serious environmental problems. Millions of tons of these non-degradable plastics accumulate in the environment every year2. It is clear from this figure that the long term deleterious environmental impacts caused by plastics were entirely overlooked and this in turn poses greater difficulties for plastic waste accumulation3. A number of biodegradable thermoplastic polyesters are emerging out as a boon to overcome the problems of plastic waste accumulation. One of these promising materials is poly ((R)-3-hydroxybutyric acid) (PHB). PHB has been the subject of extensive studies as an environmentally friendly polymeric material4. PHB is a thermoplastic, belonging to the family of polyhydroxyalkanoates (PHA). It is a fully biodegradable polyester with optical activity, piezoelectricity, and very good barrier properties. PHB is a partially crystalline material with high melting temperature and high degree of crystallinity5. PHB is similar to polypropylene with three unique features: thermoplastic processability, 100% resistance to water, and 100% biodegradability6. Microorganisms provide a source of bioplastics and biopolymers (polysaccharides) from renewable sources. Although currently considerably more expensive than plastic derived from petrochemicals, bacteria have proved capable of yielding bioplastics with comparable properties. They have the additional advantage of being biodegradable. When grown under conditions where growth becomes limited through exhaustion of a key nutrient such as nitrogen or phosphorous and carbon substrate remains available, many prokaryotes can synthesize intracellular storage compounds. These act as carbon and energy reserves which can be utilized when balance growth is resumed7. Various bacterial strains capable of producing PHA have been isolated belonging to genera Pseudomonas, Acinetobacter, Sphingobacterium, Brochothrix, Caulobacter, Ralstonia, Burkholderia, and Yokenella from oil contaminated sites8. The major problem to the commercialization of PHB is its high production cost compared with conventional petroleum derived materials. In this context, extremophiles, especially halophilic microorganisms, would be an important group to investigate9. There are several advantages to working with haloarchaeal strains rather than eubacteria. Due to the high salt concentrations they require in their growth medium to maintain cell wall stability, haloarchaeal strains do not require strict sterile conditions. Cell walls can also easily lyse in the absence of salt, especially in distilled water; this property enables the recovery of PHB or other PHA forms from extreme halophiles much more easily and economically than from eubacteria10. The first case of PHB accumulation by archaea had been reported in 1970 from Dead Sea named as Halobacterium marismortui analysed by freezefracture technique11. Extremely halophilic archaebacteria (Halobacteriaceae) produce PHB under nutrient-limited conditions and abundant carbon sources12. Haloferax mediterranei, which grows at 25%(w/v) of salt concentration, produces 60 to 65% PHA of its cell dry weight (CDW) when grown in phosphate limiting conditions and glucose or sucrose as best carbon source12. Halomonas boliviensis LC1, a moderate Halophile growing at 3–15% (w/v) of salt concentration, produces higher amount of PHB up to 56% of CDW, when grown on starch hydrolysate as substrate13. Presently, a wastewater treatment system is approved as a cost effective and environmentally friendly approach for PHB production14. Research demonstrated that the accumulation of PHB is accomplished through a feast and famine approach of the substrate (carbon source). Combining wastewater with PHB production can be considered as a sustainable approach when dealing with environmental and economic issues15. Hence the objective of this study is to isolate PHB producing Halotolerant bacterial isolates from saline environment. Primary Screening of the PHB producing bacterial strains was done by Sudan Black B staining. The production of PHB was confirmed by FT - IR analysis and Fluorescence Microscopy. The morphological identification of the bacterial strains was done by SEM analysis and Gram’s staining. Molecular identification of the PHB producing bacterial strains was done by biochemical characterization and 16s rRNA sequencing. Large scale production of PHB was done by batch studies and bioreactor studies by using a 3L fermenter.
Materials and Methods
Collection of Soil Samples
Soil samples were collected from the proximities of VGP Golden Beach and Neelankarai Beach, Chennai. The samples were collected in sterile zip lock covers and were immediately transferred to the laboratory and stored at 4°C.
Enrichment and Isolation of PHB Producing Bacterial Strains
1g of soil sample collected was inoculated in Nitrogen-deficient medium without agar16. The samples were then serially diluted in sterile distilled water and inoculated onto the Nitrogen Deficient Agar medium through pour plate technique. The plates were incubated at 37° C for 24 hours. Individual pure culture colonies were picked up from the bacterial consortium and plated on to the Nutrient Deficient Medium and incubated for 24 – 48 hours.
Screening of PHB Producing Bacterial Strains
Sudan Black B Staining
Bacterial smears were made on sterile glass slides, heat fixed and stained with an ethanolic solution of Sudan Black B to visualize the PHB granules. The prepared smears of the cultures were stained for 10 minutes with Sudan Black solution. The slides were then washed with running tap water and air dried. It was then counter stained with 0.5% Safranin for 5 minutes and washed with running water17.
Fluorescence Microscopy
The bacterial samples were smeared on glass slides, air dried and heat fixed. The smear was flooded with 1% Nile blue A and heated in a water bath at 55°C for 10 minutes. The stain was washed off with water and 8% aqueous solution of acetic acid for 1 minute. The slide was air dried and observed under a fluorescence microscope at an excitation wavelength of 460 nm18.
Extraction of PHB
After 72 hours of incubation at 37°C in Nitrogen Deficient Medium, the culture broth was centrifuged at 8000 rpm for 15 minutes. The pellet along with 10 ml Sodium hypochlorite solution was incubated at 50°C for 1 hour for lyses of cells. The cell extract obtained was centrifuged at 12000 rpm for 30 minutes and then washed sequentially with distilled water, acetone and absolute ethanol. After washing, the pellet was dissolved in 10 ml chloroform and incubated at 50°C overnight and evaporated at room temperature. After evaporation, 10 ml of sulphuric acid was added to it and placed in water bath for 10 minutes at 100°C. This converts the PHB into crotonic acid, which gives maximum absorption at 235 nm using sulphuric acid as blank2.
Quantification of PHB by Spectrophotometry
The extracted PHB was quantified by Crotonic acid assay19. Crotonic acid powder was dissolved into 3 ml of sulphuric acid and standard solution of 0.1µg of Crotonic acid/µl of sulphuric acid was prepared. Working standards of 5, 10, 15, 20, 25, 30, 40, 50µg/3ml of sulphuric acid were prepared. Blank was prepared by adding 3 ml of sulphuric acid. The absorbance was measured at 235 nm. Standard graph of concentration v/s absorbance was prepared.
Analysis of PHB by FT – IR Spectroscopy Method
FT – IR analysis was carried out in an IR Affinity – 1, Shimadzu in Ethiraj College for Women, Chennai. The spectrophotometer was operated in the range of 4000 – 500 cm-1.
Characterization and Identification of Bacterial Strains
SEM Analysis
The isolated bacterial strains were grown individually on MSM for 24 hours. The bacterial strains in the Mineral Salts Medium were centrifuged at 8000 rpm for 10 minutes and the pellets were immediately re – suspended in 2% Glutaraldehyde with 0.05 M phosphate buffer and 4% sucrose (pH – 7.3). Fixation was obtained overnight at 4°C. After 24 hours the pellets were centrifuged at 8000 rpm for 10 minutes, washed 4 times with distilled water and placed on aluminium foil. The samples were then dehydrated with series of gradient ethanol (10%, 20%, 30% till 90%) air dried and finally the dried flakes were analyzed under the Scanning Electron Microscope (FEI Quanta 200 F). The analysis was performed in IIT Madras, Guindy.
Morphological and Biochemical Characterization of Bacterial Strains
The bacterial strains were morphologically identified by Gram’s Staining and further characterized by various biochemical tests such as Catalase test, Oxidase test, IMViC tests, Triple Sugar Iron Agar test, Starch Hydrolysis Test and Carbohydrate Fermentation test.
Molecular Identification of Bacterial Strains
The isolated bacterial strains were morphologically characterized and identified by DNA isolation, 16s rRNA sequencing and construction of phylogenetic tree.
Bioreactor Studies to Increase PHB Production by the Efficient Bacterial Strain
Wastewater Analysis
To study the production of PHB by fed batch process in wastewater using molasses as a carbon source. The composition of wastewater is given as follows: (mg/l) Glucose – 500, Sodium hydrogen carbonate – 300, Ammonium hydrogen carbonate – 50, Potassium dihydrogen phosphate – 22.5, Magnesium sulphate – 50, Manganese sulphate – 0.03, Zinc sulphate – 0.04, Calcium chloride – 1, Ferric chloride – 0.32 and Yeast extract – 50. Blackstrap molasses was obtained in 500 ml volume from Dhanyam, Chennai.
Batch Studies on Wastewater Analysis
In a 250 ml Erlenmeyer flask, 100 ml of sterilized wastewater with 4% molasses20 was inoculated with 4% concentration21 of the efficient halotolerant bacterial strain (NFKVG 8). The culture flask was then incubated at 37°C for 3 days at 150 rpm. Protein estimation and PHB production was done from Day 0 to Day 3 and the results were recorded. To further scale up the production of PHB, 250 ml of the sterilized wastewater was taken in a 500 ml Erlenmeyer flask with the same concentration of molasses and inoculum. The culture flasks were incubated in a shaker for 3 days at 150 rpm. Protein estimation and PHB production was done on all the three days and the results were recorded.
Bioreactor Study for Large Scale Production of PHB
For the large scale production of PHB, a bench scale bioreactor of 3L capacity was used for the laboratory study on PHB production under saline conditions. The experimental setup was as follows:
Wastewater – 2.5 litres
Molasses – 100 ml (4% concentration)
Broth culture of bacterial strain – 100 ml (4% concentration)
pH – 7.5 – 8.0
Temperature - 37°C
The bench scale reactor was continuously aerated with constant agitation using the agitator provided in the fermeter at 500 rpm. The wastewaster sample from the reactor was analysed for the physico – chemical parameters such as pH, salinity, TDS using an external pH probe, total protein (Bradford’s procedure), chloride, hardness, Dissolved oxygen 22.
Results and Discussion
Enrichment and Isolation of Bacterial Strains for PHB Production Under Halotolerant Conditions
Enrichment of the bacterial cultures was performed in Nitrogen Deficient Medium under halotolerant conditions with 3% NaCl. A total of 16 isolates were obtained, out of which 10 isolates were obtained from VGP soil samples and 6 were obtained from Neelankarai Beach samples. Out of the 16 isolates, 2 bacterial isolates (NFKVG 8 and NFKVG 10) screened positive for PHB production by Sudan Black B staining. Figure 1 shows the enriched NDA plate in 10-7 dilution from which the two PHB producing bacterial isolates under halotolerant conditions were obtained. A wide variety of bacteria are known to accumulate PHB granules intercellularly as an energy reserve material. Microbial species from over 90 genera have been reported to accumulate approximately 150 different hydroxyalkanoates as polyesters granules 23.
Primary Screening of PHB Producing Bacterial Strains
Sudan Black B staining
Primary screening was done in order to determine the PHB production of the bacterial strains. These strains were further used for the analysis of PHB polymer. Both the bacterial strains NFKVG 8 and NFKVG 10 accumulated PHB in the form of intracellular granules and these granules were able to absorb the Sudan Black stain and the cell wall of the strains was stained pink as a result of the counter stain used. Under magnification of 100 x it was seen that the granules were stained black against a pink background taken up by the Safranin stain (Figure 2). The observation of these darkly stained granules determined the production of PHB in the bacterial strains. For the rapid detection of PHB producing bacteria, 0.02% alcoholic solution of Sudan Black B stain was used24. It was reported that a total of 120 isolates showed black – blue coloration when stained with Sudan Black B, a preliminary screening agent for lipophilic compounds 2.
Figure 2.Microscopic observation of PHB granules produced in the bacterial strain
Growth Pattern of PHB Producing Bacterial Strains
The individual bacterial strains were grown in Minimal Salt Medium (MSM) to study the growth pattern and also to determine the PHB yield. It was shown that the individual bacterial strains showed maximum growth for the bacterial strain NFKVG 8 – 0.668 and NFKVG 10 – 0.621 respectively (Figure 3) and the PHB yield was seen to be maximum on the third day of incubation - 50 mg/100ml for the bacterial strain NFKVG 8 and 37 mg/100ml for NFKVG 10 (Table 1).
Figure 3.Growth pattern of P/HB producing bacterial strains
| STRAIN NO | GROWTH ( O.D at 540 nm) | PHB YIELD (mg/100ml) |
| NFKVG 8 | 0.997 | 50 |
| NFKVG 10 | 0.986 | 37 |
Secondary Screening of PHB Producing Bacterial Strains by Fluorescence Microscopy
The Sudan black B stained positive bacterial strains were further screened by Nile Blue A, a more specific stain for PHB production which is a more rapid and sensitive method. After staining with Nile Blue A, the PHB accumulating granules showed bright orange fluorescence on irradiation with UV light. Hence the fluorescence of PHB granules was checked from Day 0 to Day 3 to determine the increase in the PHB production. The fluorescence intensity increased with the increase in PHB content of the bacterial strains. The fluorescence was observed under 100 x magnification (Figure 4). PHB granules exhibited a strong orange fluorescence when stained with Nile Blue A 18. It was also reported that a total of 62 isolates showed positive result with Nile Blue A staining, a specific dye for the presence of PHB granules. The PHB accumulating colonies after Nile Blue A staining, showed bright orange fluorescence on irradiation with UV light and their fluorescence intensity increased with increase in the PHB content of the bacterial cells2.
Figure 4.PHB granules observed under Fluorescence Microscope by the bacterial strain
Polymer Determination by FT IR Spectroscopy Method
FT – IR spectra of the PHB production predicts the presence of functional groups of PHB 25i.e., aliphatic C – H, = O stretching, = C – H deformation and = C – O. PHB and their copolymers have known to contain these functional groups26.PHB polymer extracted from the bacterial strains was used for recording the IR Spectra in the range of 4000 – 500 cm-1 (Figure 5). The spectrum showed intense absorption at the range of 1744 – 1030 cm-1 for the bacterial strains which shows the aliphatic nature of the PHB produced. The spectrum also showed the absorption bands of O – H stretching in the range of 3404 – 3411 cm-1 which was variable and sharp. In addition, the spectrum showed absorption bands of C – H stretching in the range of 2927 – 2860 cm-1 which was medium and variable (Table 2). It was reported the absorption band during FT – IR analysis from 2924 cm-1 to 2854 cm-1 stretching as aliphatic C – H band. The absorption band obtained at 1608 cm-1 as C = O stretching, the bands obtained at 1460 cm-1 as C – H of CH3 stretching27.
Figure 5.FT – IR spectrum of the bacterial strains for PHB production
| PEAK VALUE cm -1 | FUNCTIONAL GROUP | INTENSITY |
|---|---|---|
| 3411.26 | O – H stretch | Variable, broad |
| 2923.25 | C – H stretch | Strong |
| 2860.56 | C – H stretch aldehyde | Variable |
| 1455.35 | C – H alkane | Variable |
| 1030.03 | C – O stretch | Strong |
Quantification of PHB by UV – Spectrophotometric Analysis
To quantify the production of PHB, Crotonic acid was used as a standard at concentrations ranging from 5 – 50 µg/ml (Figure 6). Table 3 gives the optical density of the substrate increasing from 0.532 at 50µg/ml concentration to 0.971 at 500µg/ml of Crotonic Acid.
Figure 6.Standard graph of Crotonic acid assay for the quantification of PHB
| S.NO | Crotonic acid µl | Sulphuric acid ml | Concentration µ g/ml | O.D value at 235 nm |
| 1 | - | 3 | - | 0 |
| 2 | 50 | 2.950 | 5 | 0.532 |
| 3 | 100 | 2.900 | 10 | 0.687 |
| 4 | 150 | 2.850 | 15 | 0.790 |
| 5 | 200 | 2.800 | 20 | 0.878 |
| 6 | 250 | 2.750 | 25 | 0.891 |
| 7 | 300 | 2.700 | 30 | 0.934 |
| 8 | 400 | 2.600 | 40 | 0.959 |
| 9 | 500 | 2.500 | 50 | 0.971 |
Characterization and Identification of Bacterial Strains
SEM Analysis
SEM analysis was carried out to determine the morphological structures of the bacterial strains. The ultra structure of the bacterial strains NFKVG 8 and NFKVG 10 was observed under 11000 x magnification and it was seen that the strains showed rod shaped morphology (Figure 7).
Figure 7.Morphology of NFKVG 8 and NFKVG 10 under 11000 x magnification
Biochemical C haracterization and M olecular I dentification of the PHB P roducing B acterial S trains
According to the results of the various biochemical tests that were performed, the individual bacterial isolates were classified upto the genus level and they were characterized to belong in the Acinetobacter sp(Table 4). For further characterization, 16 s rRNA gene sequences were determined. The obtained sequences were compared with the available sequences in the NCBI database using BLAST program and the bacterial strains were identified to be as NFKVG 8 – Acinetobacter iwoffii(KX622778)and NFKVG 10 – Acinetobacter baumannii(KX622779). The phylogenetic analysis was carried out by using the MEGA 6.0 software to determine the evolutionary distances between the bacterial strain (Figure 8). It was reported that the PHB positive isolates were identified to be Pseudomonas sp. based on the Bergey’s manual of determinative Bacteriology 28.
Figure 8.Phylogenetic analysis of the bacterial strains NFKVG 8 and NFKVG10
| CHARACTERISTICS | NFKVG 8 | NFKVG 10 |
|---|---|---|
| Gram’s staining | -ve | -ve |
| Motility | - | - |
| Catalase | + | + |
| Oxidase | + | + |
| Indole | - | + |
| Methyl Red | + | + |
| Voges Proskauer | - | - |
| Citrate utilization | - | - |
| Triple Sugar Iron | Alkaline slant and butt | Alkaline slant and butt |
| Starch hydrolysis | - | - |
| Carbohydrate Fermentation Glucose | + | + |
| Galactose | - | - |
| Lactose | - | - |
| Maltose | - | - |
| Sucrose | + | + |
| Xylose | - | - |
Bioreactor Studies to Increase PHB Production by the Efficient Bacterial Strain NFKVG 8
Bioreactor studies for the large scale production of PHB were carried out first in 250 ml and 500 ml Erlenmeyer flasks with the most efficient bacterial strain – NFKVG 8. Water analysis was done for the wastewater which was used for the scale up in the production of PHB (Table 5). For the large scale production of PHB, the bacterial strain NFKVG 8 was inoculated with sterilized wastewater in 250 ml and 500 ml flasks and then in a 3L fermenter. The total protein content and PHB production was determined for both the batch studies as well as the fermenter setup and the results were recorded (Figure 9). PHB production was done and the amount of PHB was quantified in the shaker flasks and the laboratory scale fermenter. It was seen that the /PHB content increased as the volume of the wastewater increased from 18 mg/100 ml in the shaker flasks to 75 mg/100 ml in the fermenter (Figure 10). It was reported that the PHB production from wastewater obtained from different sources like sugar and pulp industry. In their study amount of PHB produced was found to be 77 – 80 % (w/w) of dry cell weight15
Figure 9.Protein content of the bacterial strain NFKVG 8 in wastewater
Figure 10.PHB yield of the bacterial strain NFKVG 8 from wastewater
| pH | 7.5 |
| Temperature | 29.7°C |
| Conductivity | 1413 mScm-1 |
| Total Dissolved Solids | 250 ppm |
| Salinity | 171 ppm |
| Dissolved Oxygen | 1.8 ppm |
| Hardness | 16.4 ppm |
| Chloride | 61 ppm |
Conclusion
PHB is the most popular and the best characterized polymer belonging to the class of polyhydroxyalkanoates. It could be used for applications similar to those of common plastics and could fit well into new waste-manageable strategies as well. The recovery of PHB from the cell wall of extreme halophiles is much easier when compared with eubacteria. Hence in this study, halotolerant bacterial strains were isolated from marine soil and the PHB production was compared in both the bacterial strains. The efficient bacterial strain was used in the large scale production of PHB using wastewater. The future perspectives of this study would be to employ novel methods of PHB production which are both cost – effective and environmentally friendly. This could be done by commercializing the production of PHB by using wastewater as the substrate for the production of PHB.
References
- 1.Rasheed Risha, Latha D.Devi Ramachandran and Gowri GR (2013). Characterization of biopolymer producing Streptomyces parvulus, Optimization of process parameters and mass production using less expensive substrates. International Journal of Bioassays. doi: 10.21746/ijbio.2013.04.0017 ISSN: 2278 – 778x .
- 2.Anish Kumari Bhuwal, Singh Gulab, Neeraj Kumar Aggarwal, Goyal Varsha, Yadav Anita. (2013) . Isolation and Screening of Polyhydroxyalkanoates Producing Bacteria from Pulp, Paper, and Cardboard Industry Wastes. Int J Biomater. PMCID: PMC3830821 10-1155.
- 3.Kunasundari B, Sudesh K. (2011) Isolation and recovery of microbial polyhydroxyalkanoates. eXPRESS Polymer Letters. DOI: 10.3144/expresspolymlett.2011.60 5(7), 620-634.
- 4.Ansari Sabbir.and Tasneem Fatma (February2014) Polyhydroxybutyrate – a Biodegradable Plastic and its Various Formulations. , International Journal of Innovative Research in Science, Engineering and Technology.Vol.3,Issue2 doi:, 2014-68.
- 5.Mohamed Ahmed.El-Hadi Abdel Ghaffar (2002) Development of biodegradable materials based on Poly (3-. Hydroxybutyrate) PHB. der Mathematisch - Naturwissenschaftlich - Technischen Fakultät der Martin-Luther Universität Halle-Wittenberg von Diplomphysiker. DOI: https://sundoc.bibliothek.uni-halle.de/ diss-online/02/02H017/prom .
- 6.Hrabak O. (1992) Industrial production of Poly-β-hydroxybutyrate. , Federation of European Microbiological Societies0168-6445/92 251, 256-10.
- 7.Ian W Sutherland. (2010) Bioplastic and Biopolymer production. doi: http://www.eolss.net/sample-chapters/c17/E6-58-05-05. Vol V, Ch-17 , Encyclopedia of Life Support Systems, Biotechnology
- 8.Baljeet Singh Saharan. (2014) Anita Grewal and Pardeep Kumar (2014). Biotechnological Production of Polyhydroxyalkanoates: A review on Trends and Latest Developments. Hindawi Publishion Corporation. Article ID , Chinese Journal of Biology Volume, 802984-10.
- 9.Ramezani Mohaddeseh. (2015) Mohammad Ali Amoozegar, Antonio Ventosa (2014). Screening and comparative assay of poly-hydroxyalkanoates produced by bacteria isolated from the Gavkhooni Wetland in Iran and evaluation of poly-β-hydroxybutyrate production by halotolerant bacterium Oceanimonas sp. GK1. Ann Microbiol 65, 517-526.
- 10.Tekin Ebru, Ates Mustafa. (2012) Ozge Kahraman (2011). Poly-3-hydroxybutyrate-producing extreme halophilic archaeon: Haloferax sp. MA10 isolated from Çamaltı Saltern. , İzmir. Turk J Biol 36, 303-312.
- 11.R G Kirk, Ginzburg M. (1972) Ultrastructure of two species of Halobacterium. , Journal of Ultrastructure Research,Volume41,No.1–2 80-94.
- 12.Fernandez–Castillo R, Rodriguez–Valera F, Gonzales-RamosJ Ruiz–Berraquero, F. (1986) Accumulation of Poly (β – hydroxybutyrate) by Halobacteria. , Applied and Environmental Microbiology 51, 214-216.
- 13.Quillaguaman J, Hashim S, Bento F, Mattiasson B, Hatti–Kaul R. (2005) Poly (β – hydroxybutyrate) production by a moderate halophile, Halomonas boliviensis LC1 using starch hydrolysate as a substrate. doi: 10.1111/j.1365-2672.2005.02589.x. , Journal of Applied Microbiology 99(1), 151-157.
- 14.Phasakanon Jongrak, Chookietwattana Kannika, Dararat Somchai. (2013) Polyhydroxyalkanoate 1. Production from Sequencing Batch Reactor System Treating Domestic Wastewater Mixed with Glycerol Waste. , APCBEE Procedia 8(2014), 166-10.
- 15.Yuan Qiuyan, Sparling Richard, Oleszkiewicz Jan. (2015) Polyhydroxybutyrate Production from Municipal Wastewater Activated Sludge with Different Carbon Sources. , Air, Soil and Water Research 2015, 53-58.
- 16.Patnayak S, Sree A. (2005) Screening of Bacterial Associates of Marine Sponges for Single Cell Oil and PUFA. , Lett Appl Microbiol 40(5), 358-363.
- 17.Kumari Priya, Harish Kumar Dhingra. (2013) Isolation and Characterisation of PHB Producing Micro-organisms Isolated from Root Nodules of Leguminous Plants. , The Bioscan 8(1), 109-113.
- 18.Anthony G Ostle, J G Holt. (1982) Nile Blue A as a Fluorescent Stain for Poly-β-Hydroxybutyrate. DOI: http://www.ncbi.nlm.nih.gov/pmc/articles/PMC241995/ , Applied and Environmental Microbiology 44(1), 238-241.
- 19.Hiremanth Lingayya, Narendra Kumar S, H N Ravishankar, Angadi Swathi, Sukanya P. (2015) Design, Screening and Microbial Synthesis of Bio-polymers of Polyhydroxybutyrate from low cost carbon sources. doi: http://www.journalijar.com/uploads/272_IJAR-5010 , International Journal of Advanced Research 3, 420-425.
- 20.Mona K, Azza E, Sanaa H Swellam, Omar Gouda. (2001) Production of PHB by a Bacillus megaterium strain using sugarcane molasses and corn steep liquor as sole carbon and nitrogen sources. , Microbiol. Res 156, 201-207.
- 21.Pranav R Kshirsagar.Rahul Suttar, Smita Shrikant Nilegaonkar, Snehal Pradhan, Pradnya P Kanekar (2012). Scale up production of polyhydroxyalkanoate (PHA) at different aeration, agitation and controlled dissolved oxygen levels in fermenter using Halomonas campisalis MCM B-1027. , Journal of Biochemical Technology.Vol4.No1 doi:, 4126.
- 22. (2001) . APHA,AWWA,WEF.Standard Method for the Examination of Water and Wastewater. 20th ed , Washington, DC.:APHA; .
- 23.Steinbuchel A, Schubert P. (1988) Expression of Alcaligenes eutrophus polyhydroxybutyric acid – synthetic pathway in Pseudomonas sp. , Arch. Microbiol.153 101-104.
- 24.Spiekermann P, BHA Rehm, Kalscheuer R, Baumeister D, Steinbuchel A. (1999) A sensitive, viable-colony staining method using nile red for direct screening of bacteria that accumulate polyhydroxyalkanoic acids and other lipid storage compounds. doi: 10.1007/s00203005068. , Arch Microbiol 171, 73-80.
- 25.Sei K H, Yong K C, Sang Y L. (1994) Recovery and characterization of poly beta hydroxybutyric acid synthesized in Alcigenes eutrophus and recombinant E.coli. Application in environmental microbiology. 611-34.
- 26.Parshad I, Garson T, Patel J J, Wong M N. (2001) The regulation of PHB metabolism in Azotobacter beijernickii. , Applied Environmental Microbiology 125, 75-78.
Cited by (10)
This article has been cited by 10 scholarly works according to:
Citing Articles:
Fuel (2025) OpenAlex
Fuel (2025) Crossref
Nafiseh Elmi Fard, Alireza Sarkar, Nader Hasanzadeh - Fuel (2025) Semantic Scholar
Cleaner Materials (2024) OpenAlex
Oluwafemi Adebayo Oyewole, Shehu Usman Abdulmalik, Asiya Onozasi Abubakar, Konjerimam Ishaku Chimbekujwo, Yemisi Dorcas Obafemi et al. - Cleaner Materials (2024) Semantic Scholar
The Microbe (2024) OpenAlex
The Microbe (2024) Crossref
S. Adebajo, P. Bankole, A. Ojo, P. Akintokun - The Microbe (2024) Semantic Scholar
Biotechnology Advances (2022) OpenAlex
Biotechnology Advances (2022) Crossref
S. Obruča, P. Dvořák, P. Sedláček, M. Koller, K. Sedlář et al. - Biotechnology Advances (2022) Semantic Scholar
Brazilian Journal of Microbiology (2021) OpenAlex
Brazilian Journal of Microbiology (2021) Crossref
Saba Amiri, M. Mohammadi Zeydi, N. Amiri - Brazilian Journal of Microbiology (2021) Semantic Scholar